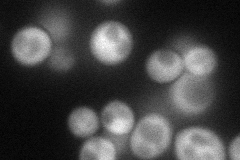
YOR143C
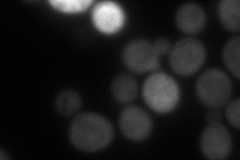
YOR143C
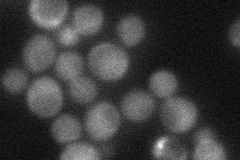
YOR143C
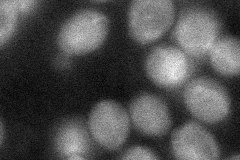
YOR143C
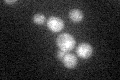
YOR143C

View description
Thiamine pyrophosphokinase, phosphorylates thiamine to produce the coenzyme thiamine pyrophosphate (thiamine diphosphate)
Localization:
Intensity:
Fold change:
Significance:
-
C’ GFP library in SD

cytosol26.55 -
N' NOP1pr-GFP in SD
cytosol79.8537 -
N' TEF2pr-mCherry in SD
cytosol101.697 -
N' NATIVEpr-GFP in SD
cytosol35.9481 -
N' TEF2pr-VC and Cyto-VN in SD
cytosol45.3997 -
C’ GFP library in SD+DTT

cytosol26.110.98No -
C’ GFP library in SD+H2O2

cytosol28.241.06No -
C’ GFP library in Starvation Media
cytosol36.031.35No -
C’ GFP library on the background of Pup2-DaMP

cytosol -
C’ GFP library on the background of CCT mutant

cytosol24.11350.907855No
